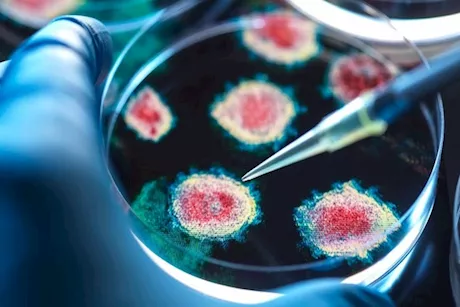
فيروس كورونا جديد.. تحذير عالمي من تهديد وبائي محتمل

أخبار متعلقة بــ
فيروس كورونا الجديد
-
متحوّر كورونا جديد.. "ستراتوس" يثير الرعب في بريطانيا

نستعرض كل ما نعرفه حتى الآن عن متحوّر "ستراتوس"، ومدى خطورته، وأثره المحتمل على فاعلية اللقاحات، وفقًا لموقع "independent" البريطاني.
-
فيروس كورونا جديد.. تحذير عالمي من تهديد وبائي محتمل
سلطت دراسة حديثة نُشرت في مجلة Nature Communications الضوء على خطر متزايد يهدد البشر من فيروسات الخفافيش، وتحديدًا مجموعة تُعرف باسم فيروسات "HKU5"، والتي تنتمي إلى نفس عائلة فيروس كورونا
- المزيد
مختارات لا تفوتك
-
 نصائح
نصائحاليوم العالمي لمكافحة التدخين 2026- 6 بدائل طبيعية لنيكوتين السجائر
اليوم العالمي للتدخين 2026. اليوم العالمي لمكافحة التدخين 2026. اليوم العالمي للتدخين. اليوم العالمي للإقلاع عن التدخين. بديل النيكوتين الطبيعي. بدائل النيكوتين.
-
 صور و فيديوهات
صور و فيديوهاتالجوع بعد الأكل مباشرة- خبير تغذية يوضح أبرز أسبابه "فيديو"
الجوع بعد الاكل. الجوع بعد الاكل مباشرة. سبب الجوع بعد الاكل مباشرة. اسباب الجوع بعد الاكل مباشرة. سبب الجوع بعد الاكل. اسباب الجوع بعد الاكل. احساس الجوع بعد الاكل.
-
 صور و فيديوهات
صور و فيديوهاتطريقة حفظ لحم العيد- كيف تحميها من التلف؟ "فيديوجرافيك"
كيفية حفظ لحم الاضحية. كيفية حفظ لحم الأضحية. طريقة حفظ لحم العيد. طريقة حفظ لحمة العيد. طريقة حفظ لحم الاضحية. طريقة حفظ لحوم الأضاحي. حفظ لحوم الاضاحي.
-
 نصائح
نصائحطبيب يحذر: شرب الماء بهذه الطريقة يهدد الجسم ببعض الأضرار
شرب الماء بسرعة اضرار شرب الماء بسرعه شرب الماء سريعا شرب المياه بسرعه مخاطر شرب الماء بسرعة مخاطر شرب المياه بسرعة أضرار شرب المياه بسرعة تأثير شرب الماء بسرعة على الجسم
-
 أمراض مزمنة
أمراض مزمنةتأثير دهون الكبد على الجسم- طبيب يجيب: هل ترفع الكوليسترول؟
دهون الكبد والكوليسترول. علاقة دهون الكبد بالكوليسترول. تأثير دهون الكبد على الجسم. ارتفاع الكوليسترول ودهون الكبد. الكوليسترول ودهون الكبد. الكوليسترول والكبد الدهني.
-
 أمراض مزمنة
أمراض مزمنةأسباب سرعة ضربات القلب أثناء الراحة- طبيب يجيب: هل لها دلالات خطيرة؟
سرعة ضربات القلب اثناء الراحة. اسباب سرعة ضربات القلب اثناء الراحة. سرعة ضربات القلب عند الراحة. سبب سرعة ضربات القلب عند الراحة. سبب سرعة ضربات القلب اثناء النوم.
-
 نصائح
نصائحتنميل اصابع اليد فجأة- طبيب يحذر: قد تكون مصابًا بهذه الأمراض
تنميل أصابع اليد. تنميل أصابع اليد فجأة. سبب تنميل اصابع اليد فجأة. اسباب تنميل اصابع اليد. علاج تنميل اصابع اليد. اصابع اليد تنميل. اصابع اليد منملة. اصابع اليد منمله.
-
 أخبار عيادة العيون
أخبار عيادة العيونتورم العين لمريض السكر- طبيب يوضح أبرز أسبابه وطرق الوقاية منه
سبب تورم العين لمريض السكر. تورم العين لمريض السكر. تورم العين بسبب السكر. انتفاخ العين لمرضى السكر. سبب انتفاخ العين لمرضى السكر. انتفاخ العين والسكر.
-
 أخبار صحة
أخبار صحةبمشاركة طب قصر العيني- ابتكار عملية بديلة لجراحات القلب المفتوح
طب قصر العيني. فريق بكلية طب قصر العيني يشارك في ابتكار عملية بديلة لجراحات القلب المفتوح. فريق بطب قصر العيني يشارك في تطبيق عملية فونتان عبر القسطرة.
-
 أخبار صحة
أخبار صحةهل الأدوية الشائعة تؤثر على تحليل المخدرات؟- هيئة الدواء تجيب
تعقيب هيئة الدواء حول تأثير الأدوية الشائعة على نتائج تحليل المخدرات. تأثير الأدوية الشائعة والمتداولة على تحليل المخدرات. الأدوية الشائعة وتأثيرها على تحليل المخدرات.











